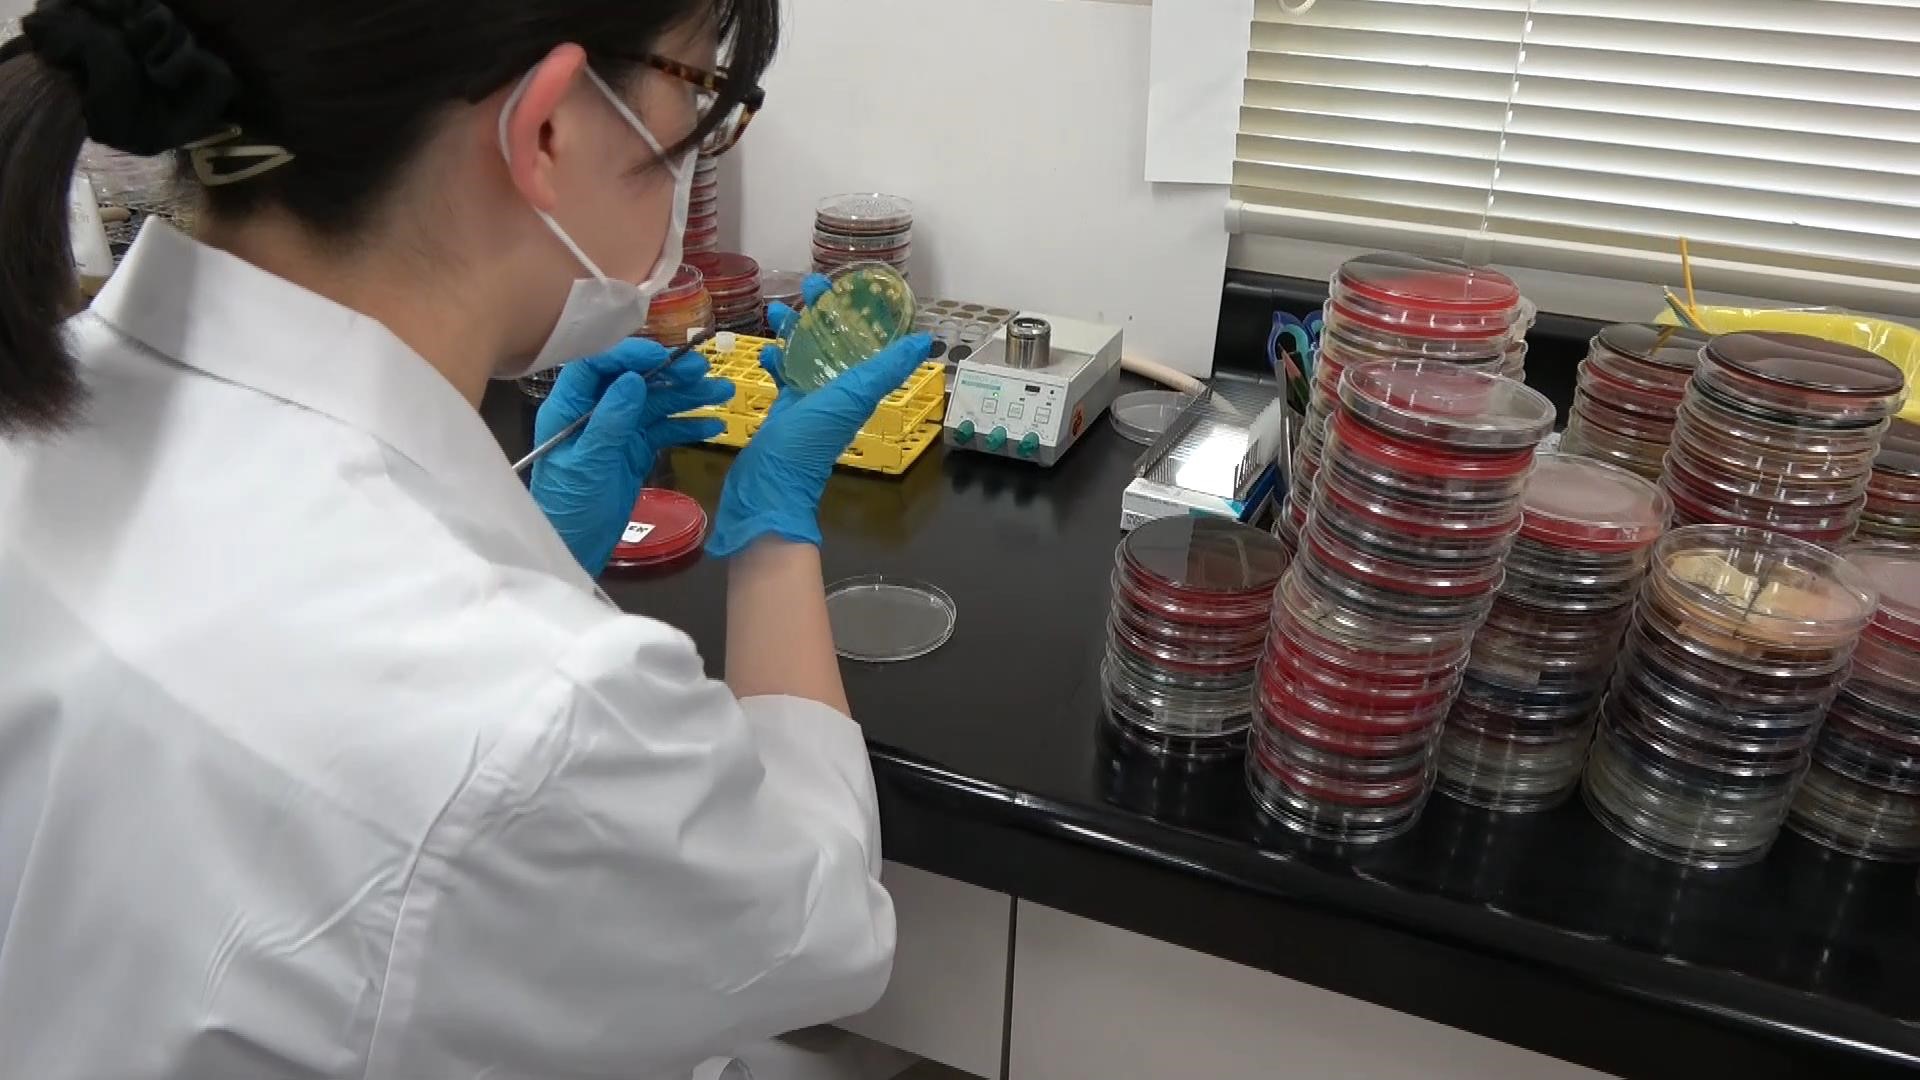

中央検査部
中央検査部のご案内
中央検査部について
中央検査部では診断・治療に必要なデータを正確・迅速に臨床に提供しています。血液や尿の検査、感染症や遺伝子の検査、がんを診断する検査、心電図や超音波の検査、輸血や採血など極めて広い分野の業務を担当しています。その他にも感染対策、栄養管理、糖尿病療養などのチーム医療や健診業務にも積極的に取り組んでいます。
通常の検査は採血後1時間以内に結果を報告できる体制で実施しています。また、夜間休日を含め24時間体制で実施しています。
スタッフは高度の知識と技術の習得はもちろん、人にやさしく接することの大切さを心掛け、常に安全安心の医療を提供するために頑張っています

生理検査
生理検査 (健診業務を含む)は、体内の情報を画像化・数値化して体の状態を直接調べる検査です。
心電図検査・呼吸機能検査
不整脈や肺活量、動脈硬化等を調べます。
項目:ホルター心電図、トレッドミル、呼気NO、血圧脈波、皮膚再灌流圧など

超音波検査
体の表面から超音波をあて、臓器の状態や大きさ、血液の流れ等を調べます。
項目:腹部、心臓、血管(頸動脈や下肢静脈・動脈)、体表(乳腺や甲状腺)など

神経機能検査
脳や神経・筋から発生する電気信号を記録し、神経系の働きや異常を調べます。
項目:脳波検査、神経伝導検査、睡眠時無呼吸検査など

その他
聴力検査、術中モニタリング、新生児聴覚検査など生理検査室以外で行う検査にも関わっており、他職種のスタッフと連携して業務をしています。

化学・免疫検査

自動分析装置2台と免疫測定装置2台が搬送機と連結し、測定から検体保管までを行い、肝機能や腎機能の項目、腫瘍マーカーやホルモンなど70項目以上の検査を実施しています。
また夜間、休日も60項目以上の検査に24時間対応しています。
感染症の項目についてはコンタミネーションによる偽陽性を防ぐため、専用の採血管と独立した専用の機器を用いてスタンドアローンの検査を実施しています。
精度の高い検査データを報告するためには日頃からの機器のメンテナンス、精度管理がとても重要です。一定の精度を保つために日々の精度管理はもちろん、医師会や日本臨床検査技師会などの外部精度評価にも積極的に参加しています。
血液検査

主に血液の有形成分(血球)を検査する「血球数算定検査(血算)」と液体成分(血漿)を検査する「凝固・線溶検査」を実施しています。
当院は診療科に血液内科を有しており、骨髄検査も高い頻度で実施しています。
骨髄穿刺は病棟や外来に検査技師が出向き、医師によって採取された骨髄の標本をその場で作製します。
骨髄検査では疑われる疾患により、普通染色の他にエステラーゼ染色や鉄染色なども行っています。
細菌検査
尿、血液、喀痰、便等の検体を培養して検出された病原菌の同定・薬剤感受性を調べています。また、遺伝子検査で、コロナウイルスや結核菌、薬剤耐性菌の検査をしています。他にチーム医療の一環として、ICT(Infection Control Team)やAST(Antimicrobial Stewardship Team)に参加し、地域医療に貢献しています。
当検査室は、土日祝も必要に応じて細菌検査所属技師が出勤しています。
 |
|
一般検査

非侵襲的なスクリーニング検査として尿・便潜血検査、穿刺によって採取される体液(髄液、胸水、腹水、関節液)の検査を行います。
尿検査では分析装置を用いて定性検査と尿沈渣検査を行い、必要に応じて顕微鏡による尿中の有形成分の観察をします。
便潜血検査は免疫比濁法を利用した分析装置による大腸がんのスクリーニングをします。2回に分けて採取する2日法で検出率を上げています。
髄液検査は顕微鏡を用いて細胞分類と算定を行います。中枢神経系疾患は迅速な診断が必要であるため、緊急性の高い検査として早急に結果を出すことに努めています。
体腔液である胸水・腹水も同様に顕微鏡での細胞分類や異型細胞の有無を確認します。
関節液は血球数算定と偏光顕微鏡による結晶(痛風・偽痛風)の鑑別を行い、関節疾患の診断につなげます。
輸血検査

主に輸血用血液製剤の管理と輸血前の検査を実施しています。
輸血用血液製剤は、病院内のすべての血液専用保冷庫がコンピュータシステムを用いた厳しい温度管理のもと輸血検査部門で24時間集中監視されています。
輸血検査は、輸血検査自動分析装置を使用してABO式、Rh式などの血液型検査、不規則抗体検査、交差適合試験などを実施しています。また、コンピュータクロスマッチを導入し、迅速な血液供給体制を構築しています。
輸血機能評価認定制度(I&A制度)認定施設
スタッフ
| 中央検査部長 | 1名 |
| 技術部長 | 1名 |
| 臨床検査技師 | 48名 |
| 資格名 | 人数 |
|---|---|
| 認定血液検査技師 | 1 |
| 認定輸血検査技師 | 2 |
| 細胞治療認定管理師 | 3 |
| 認定病理検査技師 | 1 |
| 細胞検査士 | 5 |
| 国際細胞検査士 | 5 |
| 二級臨床検査士(病理) | 5 |
| 電子顕微鏡技術二級技士 | 1 |
| 専門技術師(脳波分野) | 1 |
| 専門技術師(筋電図・神経伝導分野) | 2 |
| 認定技術師(術中脳脊髄モニタリング分野) | 1 |
| 超音波検査士(消化器) | 9 |
| 超音波検査士(体表) | 6 |
| 超音波検査士(循環器) | 10 |
| 超音波検査士(泌尿器) | 5 |
| 超音波検査士(血管) | 4 |
| 超音波検査士(健診) | 5 |
| 認定心電図専門士 | 1 |
| 認定心電検査技師 | 2 |
| 聴力検査士 | 10 |
内科系
外科系
- スポーツ整形外科
- 整形外科(関節・外傷)
- 整形外科(脊椎外科)
- 整形外科(手の外科)
- 外科・消化器外科
- 呼吸器外科
- 脳神経外科
- 乳腺外科(ブレストセンター)
- 形成外科
- 心臓血管外科
- 産婦人科
- 耳鼻咽喉科・頭頸部外科
- 眼科
- 皮膚科
- 泌尿器科
- 歯科口腔外科
- 麻酔科
その他
交通アクセス
-
最寄駅
東急東横線・目黒線 元住吉駅 徒歩7分
-
住所
〒211-8510 神奈川県川崎市中原区木月住吉町1-1
-
バス
JR横須賀線 武蔵小杉駅から約10分
JR川崎駅から約30分
JR新川崎駅から約20分
外来受付のご案内
-
受付時間
平日8:15~11:00(眼科のみ10:30まで)
-
休診日
土曜日、日曜日、祝日、国民の休日、年末年始
-
電話番号


